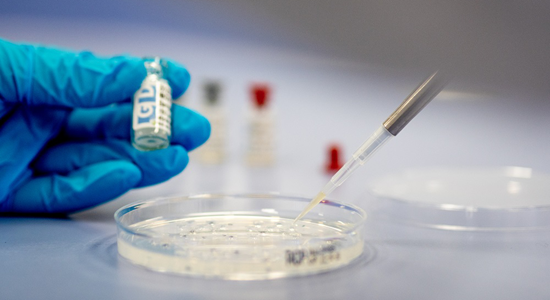

Royal GD can support your livestock business with diagnostics products. Our positive control sera are produced from naturally infected or vaccinated animals with significant antibody levels. These sera are available as assay-independent controls or ‘in-house’ controls for monitoring the performance of third-party immunodiagnostic assays on a day-to-day basis.
The Chicken reference serum 98308 (CRS) can be used for monitoring day-to-day variation in poultry antibody ELISAs. The serum is produced by GD and the CRS contains significant and known antibody levels against several major avian pathogens. A Certificate of Analysis is provided, giving specificity data and target titres for the different assays used. Our assays, antigens and antisera
Featured tests
Royal GD offers a wide range of tests and tools.

Protect your business. Safeguard your flocks. Detect avian influenza in real-time with Alveo Sense – the future of poultry diagnostics is here.
Read more

In response to the ongoing global challenge of highly pathogenic avian influenza (HPAI), we have developed veterinary diagnostic products with the latest antigens for H5N1 and H5N8 strains.
Read more
Our products, tests and tools
Proficiency testing schemes
Proficiency testing is an inter-laboratory study to determine the performance of individual laboratories for specific tests and to monitor the ongoing performance of laboratories. Our clients' top 5 reasons for participating in proficiency testing schemes are:
- Evaluating the performance of the laboratory
- Maintaining/achieving accreditation to ISO 17025
- Providing additional confidence
- Identifying inter-laboratory differences
- Identifying problems
Technical support
Our R&D staff and laboratory technicians will be able to answer your technical or practical questions concerning the use of our products and the associated techniques.
They also have direct access to the day-to-day results and performance data of reagents and controls and will in all probability be using the same batches you yourself are using.
For a more veterinary-diagnostic approach or specific veterinary problems you are welcome to consult the scientific laboratory staff, specialised in the fields of veterinary immunology, virology, bacteriology, pathology and clinical chemistry.